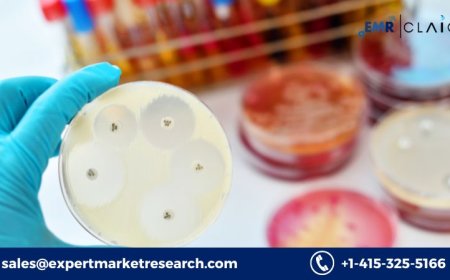

Ranitidine: What It Is and How It Works
Ranitidine played a major role in managing acid-related digestive disorders for decades. Its ability to block H2 receptors and reduce stomach acid made it a cornerstone treatment for GERD, ulcers, and heartburn.
Ranitidine 150 mg was once a household name in the treatment of acid-related digestive issues. Commonly sold under the brand name Zantac, this medication was widely used for decades to manage conditions such as heartburn, ulcers, and gastroesophageal reflux disease (GERD). However, in recent years, ranitidine has been under scrutiny due to safety concerns. Despite its withdrawal from many markets, understanding how ranitidine works and its role in medical history is still important.
This article explores what ranitidine is, how it works in the body, its uses, dosing, and the reasons behind its global recall.
What Is Ranitidine?
Ranitidine is a type of medication known as an H2 (histamine-2) receptor antagonist. It was developed in the 1970s and became available for prescription use in the early 1980s. Ranitidine was designed to reduce the amount of acid your stomach produces, providing relief for conditions related to excess stomach acid.
Over time, ranitidine gained popularity and became available as an over-the-counter (OTC) drug for treating occasional heartburn and indigestion. It was widely recommended by doctors and considered relatively safe for long-term useuntil safety concerns emerged.
How Ranitidine Works in the Body
To understand how ranitidine works, its important to know how stomach acid is produced.
The stomach contains cells called parietal cells, which produce hydrochloric acid (HCl). This acid is essential for digesting food but can cause problems when produced in excess or when it escapes into the esophagus, leading to heartburn and damage to the esophageal lining.
Histamine, a natural chemical in the body, stimulates parietal cells by binding to H2 receptors, prompting them to release stomach acid. Ranitidine works by blocking these H2 receptors, thereby reducing acid production. The result is:
-
Less acid in the stomach
-
Relief from symptoms like heartburn and indigestion
-
Healing and prevention of ulcers
-
Reduced acid reflux in the esophagus
By controlling acid levels, ranitidine helps protect the stomach and esophagus from acid damage.
Common Medical Uses of Ranitidine
Ranitidine was used to treat and prevent several digestive tract conditions, including:
1. Gastroesophageal Reflux Disease (GERD)
GERD is a chronic condition where stomach acid frequently flows into the esophagus. Ranitidine helped relieve the burning sensation (heartburn) and prevent damage to the esophageal lining.
2. Peptic Ulcers
Ranitidine was effective in treating ulcers in the stomach and duodenum (the first part of the small intestine). It also helped prevent ulcers caused by long-term NSAID use.
3. Zollinger-Ellison Syndrome
This rare condition involves tumors that cause the stomach to produce excessive acid. Ranitidine was used to help control acid production in such cases.
4. Heartburn and Indigestion
Over-the-counter ranitidine was commonly taken to treat occasional heartburn and acid indigestion, especially after meals.
Ranitidine Dosage and Administration
Ranitidine was available in various forms:
-
Tablets: 75 mg, 150 mg, and 300 mg
-
Effervescent tablets
-
Oral liquid
-
Injectable forms (in hospitals)
The dosage depended on the condition being treated. For example:
-
For heartburn: 75150 mg once or twice daily
-
For ulcers: 150 mg twice a day or 300 mg at bedtime
-
For GERD: 150300 mg twice daily
It could be taken with or without food, but consistency in timing helped maintain effectiveness.
Benefits of Ranitidine
Ranitidine gained its reputation due to several advantages:
-
Fast-acting: Many users experienced relief within 30 to 60 minutes.
-
Effective acid control: It reduced acid secretion for up to 12 hours.
-
Few immediate side effects: Most users tolerated it well when taken as directed.
-
OTC availability: Made it accessible to many without needing a prescription.
These benefits made ranitidine a go-to treatment for millions of people globally.
Safety Concerns and Global Recall
In 2019, the safety of ranitidine came into question after several testing labs, including the U.S. Food and Drug Administration (FDA), found N-Nitrosodimethylamine (NDMA) in ranitidine products. NDMA is a probable human carcinogenmeaning it could increase cancer risk if consumed in high amounts over time.
NDMA wasnt an intended ingredient but rather a contaminant that could form during storage, especially at high temperatures or over long periods.
In April 2020, the FDA requested all manufacturers withdraw ranitidine from the U.S. market, and many other countries followed suit, including India, Canada, and the European Union.
Alternatives to Ranitidine
With ranitidine pulled from shelves, patients have turned to safer alternatives, such as:
1. H2 Blockers
-
Famotidine (Pepcid) A safer option with a similar mechanism of action.
-
Nizatidine Less commonly used, but still available in some regions.
2. Proton Pump Inhibitors (PPIs)
These include:
-
Omeprazole
-
Esomeprazole
-
Pantoprazole
PPIs are more potent acid reducers but may have long-term risks like nutrient malabsorption and increased infection risk.
Ranitidine and Cancer Risk: What We Know
Although NDMA is a probable carcinogen, no direct evidence has confirmed that ranitidine use causes cancer in humans. Still, the risk from long-term NDMA exposure was significant enough for health authorities to act with caution.
Research is ongoing to assess the risk levels, but patients previously taking ranitidine are advised not to panic. The overall risk appears low, especially for short-term or occasional use.
Should You Be Concerned if You Took Ranitidine?
If youve taken ranitidine in the past:
-
Dont panic The cancer risk is low.
-
Talk to your doctor They can help assess your individual risk and recommend appropriate screenings if necessary.
-
Switch to alternatives Famotidine and PPIs are safe options when prescribed correctly.
Conclusion
Ranitidine played a major role in managing acid-related digestive disorders for decades. Its ability to block H2 receptors and reduce stomach acid made it a cornerstone treatment for GERD, ulcers, and heartburn. However, concerns about NDMA contamination led to its recall worldwide.
Today, safer alternatives are available, and patients should consult healthcare professionals to choose the right treatment. While ranitidines legacy is marked by both its effectiveness and controversy, its story is a reminder of the importance of drug safety and ongoing medical research.